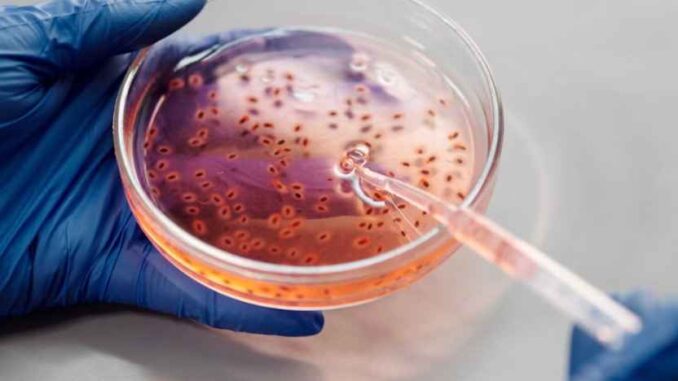

La Organización Mundial de la Salud (OMS) advirtió el pasado miércoles 31 de julio a todos los países sobre el aumento de los informes de Klebsiella pneumoniae (hvKp), una bacteria hipervirulenta. Los expertos mostraron preocupación por una cepa resistente a múltiples fármacos que, hasta el momento, no ha llegado a México.
“Las cepas que pueden causar infecciones graves en individuos sanos y han sido identificadas con creciente frecuencia en los últimos años se consideran hipervirulentas en comparación con las cepas clásicas debido a su capacidad para infectar a individuos sanos e inmunocomprometidos y debido a su tendencia creciente a producir infecciones invasivas”.OMS
¿Qué es la bacteria Klebsiella pneumoniae (hvKp)?
Klebsiella pneumoniae (K. pneumoniae, hyKp) es una bacteria Gram-negativa, perteneciente a la familia Enterobacteriaceae. Se encuentra en el medio ambiente, incluyendo:
- Suelo
- Agua superficial
- Dispositivos médicos
Ésta también se encuentra en las membranas mucosas de mamíferos y humanos; “coloniza la parte superior de la garganta y el tracto gastrointestinal“, según la organización.
Se estima que la bacteria K. pneumoniae es el agente etiológico del 20-30% de las neumonías que han requerido hospitalización en la Región de las Américas, de acuerdo con el informe del pasado 31 de julio.
Las cepas de hvKp pueden causar infecciones invasivas graves en pacientes sanos que se desarrollan rápidamente y se propagan a varias partes del cuerpo. Las infecciones también se asocian con una alta mortalidad, según la Universidad de Minnesota, Estados Unidos.
Advierten por la resistencia a fármacos de esta bacteria
Aunque las infecciones por hvKp se detectaron inicialmente en Asia y eran susceptibles a los antibióticos, informes recientes demostraron la transmisión de cepas resistentes a fármacos en entornos sanitarios de varios países.
La OMS está particularmente preocupada por una cepa de hvKp, la secuencia tipo ST23, una cepa portadora de genes que confieren resistencia a los antibióticos carbapenémicos y a todos los antibióticos betalactámicos disponibles.
Los expertos dicen que la combinación de hipervirulencia y genes de resistencia a los carbapenémicos en las cepas de K. pneumoniae es preocupante, de acuerdo con los expertos de Minnesota.
Además, la OMS señaló que las cepas ST23 compiten con otras bacterias intestinales, lo que puede facilitar la colonización y la propagación, y tienen la capacidad de generar brotes.
Aumenta el riesgo por Klebsiella pneumoniae en el mundo
La OMS afirmó en su evaluación que, con la concurrencia de la hipervirulencia y la resistencia a los antibióticos, “se espera que haya un mayor riesgo de propagación de estas cepas tanto a nivel comunitario como hospitalario”.
“Cuando se combina la resistencia a los carbapenémicos con la hipervirulencia que presentan ciertas cepas de K. pneumoniae, se obtiene una receta para aumentar la morbilidad y la mortalidad causadas por esta bacteria”.News Amesh Adalja, investigador principal del Centro de Seguridad Sanitaria de la Universidad Johns Hopkins.
Hasta el momento, 16 países informaron la presencia de cepas hvKp, estos son:
- Argelia
- Argentina
- Australia
- Canadá
- Camboya
- Región Administrativa Especial de Hong Kong
- China
- India
- Irán
- Filipinas
- Japón
- Omán
- Papua Nueva Guinea
- Gran Bretaña
- Irlanda del Norte
- Tailandia
Uno TV
